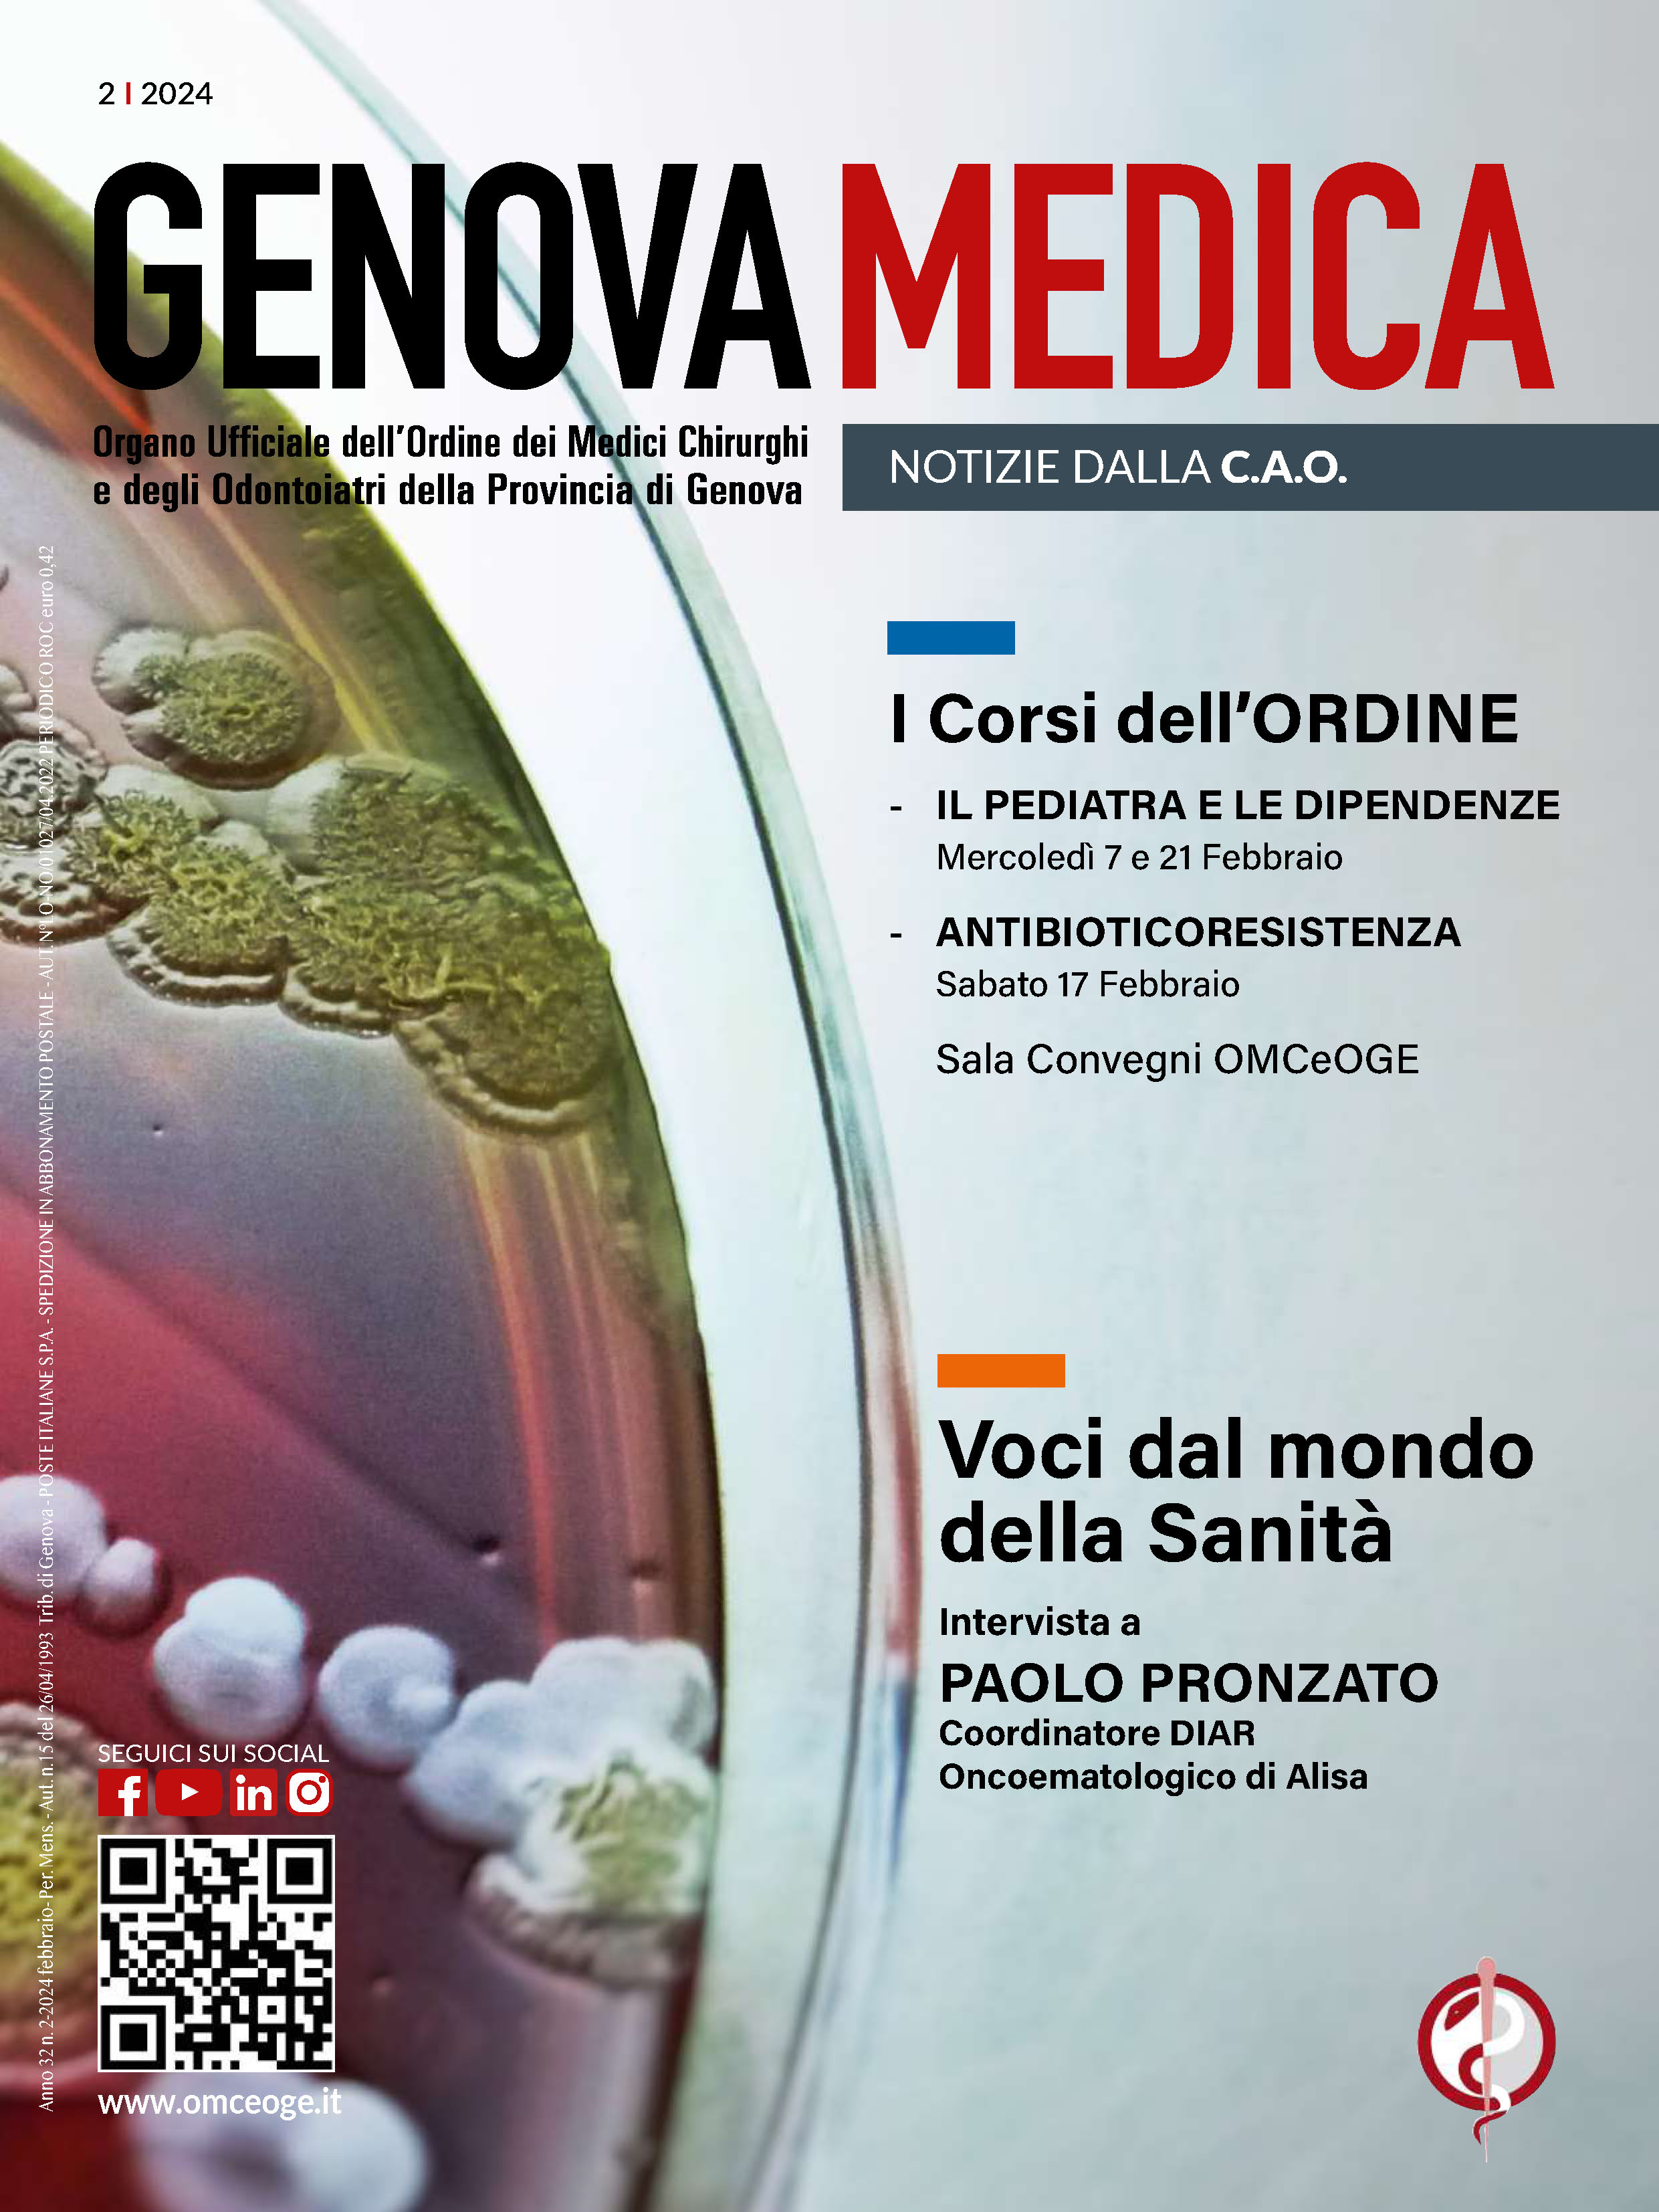
Copertina

- Marzo 2026
- Febbraio 2026
- Gennaio 2026
- Dicembre 2025
- Novembre 2025
- Ottobre 2025
- Settembre 2025
- Luglio Agosto 2025
- Giugno 2025
- Maggio 2025
- Aprile 2025
- Marzo 2025
- Febbraio 2025
- Gennaio 2025
- Dicembre 2024
- Novembre 2024
- Ottobre 2024
- Settembre 2024
- Luglio Agosto 2024
- Giugno 2024
- Maggio 2024
- Aprile 2024
- Marzo 2024
- Febbraio 2024
- Gennaio 2024
- Dicembre 2023
- Novembre 2023
- Ottobre 2023
- Settembre 2023
- Luglio Agosto 2023
- Giugno 2023
- Maggio 2023
- Aprile 2023
- Marzo 2023
- Febbraio 2023
- Gennaio 2023
- Dicembre 2022
- Novembre 2022
- Ottobre 2022
- Settembre 2022
- Luglio Agosto 2022
- Giugno 2022
- Maggio 2022
- Aprile 2022
- Marzo 2022
- Gennaio 2022
- Dicembre 2021
- Novembre 2021
- Ottobre 2021
- Settembre 2021
- Agosto 2021
- Luglio Agosto 2021
- Giugno 2021
- Maggio 2021
- Aprile 2021
- Marzo 2021
- Febbraio 2021
- Gennaio 2021
- Dicembre 2020
- Novembre 2020
- Ottobre 2020
- Settembre 2020
- Agosto 2020
- Luglio Agosto 2020
- Giugno 2020
- Maggio 2020
- Aprile 2020
- Marzo 2020
- Febbraio 2020
- Gennaio 2020
- Dicembre 2019
- Novembre 2019
- Ottobre 2019
- Settembre 2019
- Agosto 2019
- Luglio Agosto 2019
- Giugno 2019
- Maggio 2019
- Aprile 2019
- Marzo 2019
- Febbraio 2019
- Gennaio 2019
- Dicembre 2018
- Novembre 2018
- Ottobre 2018
- Settembre 2018
- Agosto 2018
- Luglio Agosto 2018
- Giugno 2018
- Maggio 2018
- Aprile 2018
- Marzo 2018
- Febbraio 2018
- Gennaio 2018
- Dicembre 2017
- Novembre 2017
- Ottobre 2017
- Settembre 2017
- Agosto 2017
- Luglio Agosto 2017
- Giugno 2017
- Maggio 2017
- Aprile 2017
- Marzo 2017
- Febbraio 2017
- Gennaio 2017
- Dicembre 2016
- Novembre 2016
- Ottobre 2016
- Settembre 2016
- Agosto 2016
- Luglio Agosto 2016
- Giugno 2016
- Maggio 2016
- Aprile 2016
- Marzo 2016
- Febbraio 2016
- Gennaio 2016
- Dicembre 2015
- Novembre 2015
- Ottobre 2015
- Settembre 2015
- Agosto 2015
- Luglio Agosto 2015
- Giugno 2015
- Maggio 2015
- Aprile 2015
- Marzo 2015
- Febbraio 2015
- Gennaio 2015
- Dicembre 2014
- Novembre 2014
- Ottobre 2014
- Settembre 2014
- Agosto 2014
- Luglio Agosto 2014
- Giugno 2014
- Maggio 2014
- Aprile 2014
- Marzo 2014
- Febbraio 2014
- Gennaio 2014
- Dicembre 2013
- Novembre 2013
- Ottobre 2013
- Settembre 2013
- Agosto 2013
- Luglio Agosto 2013
- Giugno 2013
- Maggio 2013
- Aprile 2013
- Marzo 2013
- Febbraio 2013
- Gennaio 2013
- Dicembre 2012
- Novembre 2012
- Ottobre 2012
- Settembre 2012
- Agosto 2012
- Luglio Agosto 2012
- Giugno 2012
- Maggio 2012
- Aprile 2012
- Marzo 2012
- Febbraio 2012
- Gennaio 2012
- Dicembre 2011
- Novembre 2011
- Ottobre 2011
- Settembre 2011
- Agosto 2011
- Luglio Agosto 2011
- Giugno 2011
- Maggio 2011
- Aprile 2011
- Marzo 2011
- Febbraio 2011
- Gennaio 2011
- Dicembre 2010
- Novembre 2010
- Ottobre 2010
- Settembre 2010
- Agosto 2010
- Luglio Agosto 2010
- Giugno 2010
- Maggio 2010
- Aprile 2010
- Marzo 2010
- Febbraio 2010
- Gennaio 2010
- Dicembre 2009
- Novembre 2009
- Ottobre 2009
- Settembre 2009
- Agosto 2009
- Luglio Agosto 2009
- Giugno 2009
- Maggio 2009
- Aprile 2009
- Marzo 2009
- Febbraio 2009
- Gennaio 2009
- Dicembre 2008
- Novembre 2008
- Ottobre 2008
- Settembre 2008
- Agosto 2008
- Luglio Agosto 2008
- Giugno 2008
- Maggio 2008
- Aprile 2008
- Marzo 2008
- Febbraio 2008
- Gennaio 2008
- Dicembre 2007
- Novembre 2007
- Ottobre 2007
- Settembre 2007
- Agosto 2007
- Luglio Agosto 2007
- Giugno 2007
- Maggio 2007
- Aprile 2007
- Marzo 2007
- Febbraio 2007
- Gennaio 2007
- Dicembre 2006
- Novembre 2006
- Ottobre 2006
- Settembre 2006
- Agosto 2006
- Luglio Agosto 2006
- Giugno 2006
- Maggio 2006
- Aprile 2006
- Marzo 2006
- Febbraio 2006
- Gennaio 2006
- Dicembre 2005
- Novembre 2005
- Ottobre 2005
- Settembre 2005
- Agosto 2005
- Luglio Agosto 2005
- Giugno 2005
- Maggio 2005
- Aprile 2005
- Marzo 2005
- Febbraio 2005
- Gennaio 2005
- Dicembre 2004
- Novembre 2004
- Ottobre 2004
- Settembre 2004
- Agosto 2004
- Luglio Agosto 2004
- Giugno 2004
- Maggio 2004
- Aprile 2004
- Marzo 2004
- Febbraio 2004
- Gennaio 2004
- Dicembre 2003
- Novembre 2003
- Ottobre 2003
- Settembre 2003
- Agosto 2003
- Luglio Agosto 2003
- Giugno 2003
- Maggio 2003
- Aprile 2003
- Marzo 2003
- Febbraio 2003
- Gennaio 2003
- Dicembre 2002
- Novembre 2002
- Ottobre 2002
- Settembre 2002
- Agosto 2002
- Luglio Agosto 2002
- Giugno 2002
- Maggio 2002
- Aprile 2002
- Marzo 2002
- Febbraio 2002
- Gennaio 2002
- Dicembre 2001
- Novembre 2001
- Ottobre 2001
- Settembre 2001
- Agosto 2001
- Luglio Agosto 2001
- Giugno 2001
- Maggio 2001
- Aprile 2001
- Marzo 2001
- Febbraio 2001
- Gennaio 2001
- Dicembre 2000
- Novembre 2000
- Ottobre 2000
- Settembre 2000
- Agosto 2000
- Luglio Agosto 2000
- Giugno 2000
- Maggio 2000
- Aprile 2000
- Marzo 2000
- Febbraio 2000
- Gennaio 2000
Leggi tutto...
pag.
1

